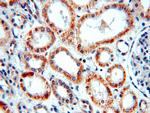
NARFL Antibody in Immunohistochemistry (Paraffin) (IHC (P))

Search
Proteintech
NARFL Polyclonal Antibody
{{$productOrderCtrl.translations['antibody.pdp.commerceCard.promotion.promotions']}}
{{$productOrderCtrl.translations['antibody.pdp.commerceCard.promotion.viewpromo']}}
{{$productOrderCtrl.translations['antibody.pdp.commerceCard.promotion.promocode']}}: {{promo.promoCode}} {{promo.promoTitle}} {{promo.promoDescription}}. {{$productOrderCtrl.translations['antibody.pdp.commerceCard.promotion.learnmore']}}
产品信息
20209-1-AP
种属反应
已发表种属
宿主/亚型
分类
类型
抗原
偶联物
形式
浓度
规格
纯化类型
保存液
内含物
保存条件
运输条件
产品详细信息
The antibody is specific to NARFL.
靶标信息
Component of the cytosolic iron-sulfur protein assembly (CIA) complex, a multiprotein complex that mediates the incorporation of iron-sulfur cluster into extramitochondrial Fe/S proteins. Seems to negatively regulate the level of HIF1A expression, although this effect could be indirect.
仅用于科研。不用于诊断过程。未经明确授权不得转售。
生物信息学
蛋白别名: Cytosolic Fe-S cluster assembly factor NARFL; Cytosolic iron-sulfur assembly component 3; HPRN; IOP1; Iron-only hydrogenase-like protein 1; LET1 like/JFP15; nuclear prelamin A recognition factor like; Nuclear prelamin A recognition factor-like protein; Protein related to Narf; unnamed protein product
基因别名: CIAO3; HPRN; IOP1; LET1L; NAR1; NARFL; PRN
UniProt ID: (Human) Q9H6Q4
Entrez Gene ID: (Human) 64428